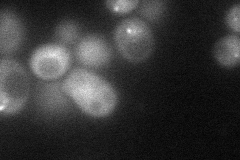
YOL104C
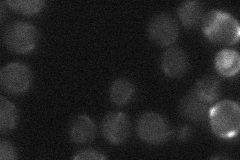
YOL104C

View description
Meiosis-specific telomere protein, required for bouquet formation, effective homolog pairing, ordered cross-over distribution, sister chromatid cohesion at meiotic telomeres, chromosomal segregation and telomere-led rapid prophase movement
Localization:
Intensity:
Fold change:
Significance:
-
C’ GFP library in SD

below threshold15.17 -
N' NOP1pr-GFP in SD
cytosol,punctate,nuclear periphery49.8005 -
N' TEF2pr-mCherry in SD

cytosol50.0466 -
N' NATIVEpr-GFP in SD
below threshold18.5678 -
N' TEF2pr-VC and Cyto-VN in SD

below threshold21.6648 -
C’ GFP library in SD+DTT

cytosol18.081.19No -
C’ GFP library in SD+H2O2

cytosol19.891.31No -
C’ GFP library in Starvation Media

cytosol24.011.58No -
C’ GFP library on the background of Pup2-DaMP

N/A -
C’ GFP library on the background of CCT mutant

N/A0N/AYes
